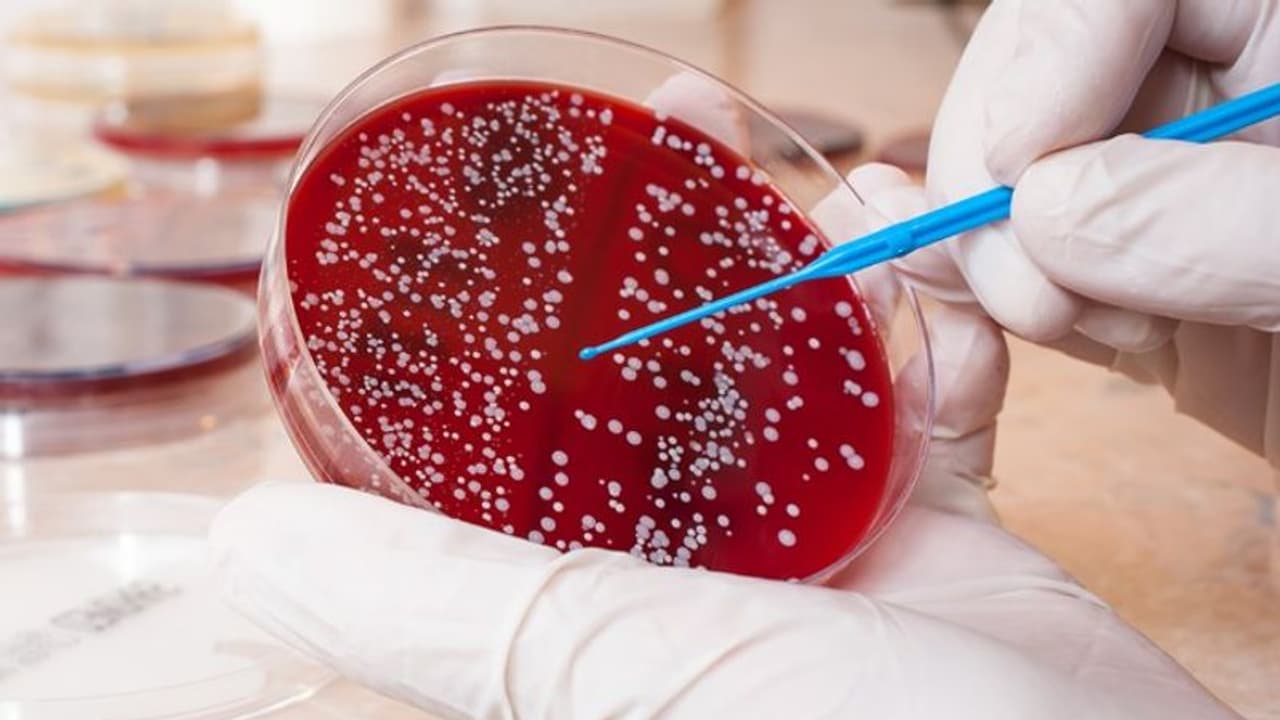

ക്യാന്സര് എത്രത്തോളം മാരകമായ അസുഖമാണെന്ന് പ്രത്യേകം പറയേണ്ടതില്ലല്ലോ. തുടക്കത്തില് കണ്ടെത്തിയാല് ഒട്ടുമിക്ക ക്യാന്സറുകളും ഭേദമാക്കാവുന്ന തരത്തില് വൈദ്യശാസ്ത്രം ഏറെ പുരോഗതി കൈവരിച്ചുകഴിഞ്ഞു.
ക്യാന്സര് എത്രത്തോളം മാരകമായ അസുഖമാണെന്ന് പ്രത്യേകം പറയേണ്ടതില്ലല്ലോ. തുടക്കത്തില് കണ്ടെത്തിയാല് ഒട്ടുമിക്ക ക്യാന്സറുകളും ഭേദമാക്കാവുന്ന തരത്തില് വൈദ്യശാസ്ത്രം ഏറെ പുരോഗതി കൈവരിച്ചുകഴിഞ്ഞു. ക്യാന്സറുകളില് ഏറെ മാരകമായ ഒന്നാണ് ബ്ലഡ് ക്യാന്സര് അഥവാ ലുക്കീമിയ. അമേരിക്കന് ജേണല് ഓഫ് ഹെല്ത്തില് പ്രസിദ്ധീകരിച്ച ബ്ലഡ് ക്യാന്സറിന്റെ ഏറ്റവും പ്രാരംഭമായ ലക്ഷണങ്ങള് എന്തൊക്കെയാണെന്ന് നോക്കാം...
1. ക്ഷീണം..
ലുക്കീമിയ ഉള്ളവരില് രക്തത്തിലെ ഹീമോഗ്ലോബിന്റെ അളവ് ക്രമാതീതമായി കുറഞ്ഞിരിക്കും. ഇത് വിളര്ച്ചയ്ക്കും, ക്ഷീണത്തിനും കാരണമാകും. എപ്പോഴും തളര്ച്ചയും തലകറക്കവും അനുഭവപ്പെടുന്നത് ഇതേ കാരണം കൊണ്ടാകും. ചിലരില് ശ്വാസതടസം അനുഭവപ്പെടുകയും ചെയ്യും.
2. നെഞ്ചുവേദനയും കാല്പ്പാദത്തിലെ നീര്ക്കെട്ടും..
ഇടയ്ക്കിടെ ഉണ്ടാകുന്ന നെഞ്ചുവേദനയും കാല്പ്പാദത്തിലെ നീര്ക്കെട്ടും ലുക്കീമിയയുടെ ലക്ഷണമാകാം. കാലിലെ നീര്ക്കെട്ടിലൂടെ രക്തസ്രാവവും ഉണ്ടാകാന് സാധ്യതയുണ്ട്. ചിലര് ഇത് ഹൃദ്രോഗലക്ഷണമായി തെറ്റിദ്ധരിക്കാറുണ്ട്.

3. പനി..
ലുക്കീമിയയുടെ ആദ്യകാല ലക്ഷണങ്ങളില് ഒന്നാണ് പനി. പെട്ടെന്ന് ശരീരത്തിലെ ഊഷ്മാവ് ഇടവിട്ട് കൂടുകയും കുറയുകയും ചെയ്യുന്നത് ഏതെങ്കിലുംതരത്തിലുള്ള അണുബാധയുടെ ലക്ഷണമാണ്. ഇതേതരത്തിലാണ് രക്താര്ബുദ ലക്ഷണമായ പനിയും കണ്ടുവരുന്നത്. ശരീരത്തില് അണുബാധയുണ്ടാകുന്നതിന് സമാനലക്ഷണങ്ങളെല്ലാം ലുക്കീമിയ പിടിപെടുമ്പോഴും തുടക്കത്തില് കണ്ടുവരാറുണ്ട്.
4. അകാരണമായ രക്തസ്രാവം..
വായ്, മുക്ക് എന്നിവയില്നിന്നും മൂത്രം, മലം എന്നിവയില്ക്കൂടിയും രക്തം വരുന്നത് ലുക്കീമിയയുടെ പ്രാരംഭ ലക്ഷണമായിരിക്കാം.
5. ശരീരത്തില് ചുവന്ന പാടുകള്..
ലുക്കീമിയയുടെ ഏറ്റവും പ്രധാനപ്പെട്ട ലക്ഷണങ്ങളില് ഒന്നാണിത്. ലുക്കീമിയ പിടിപെടുന്നവരില് രക്തത്തിലെ പ്ലേറ്റ്ലെറ്റിന്റെ അളവ് ക്രമാതീതമായി കുറയും. ഇങ്ങനെ സംഭവിക്കുമ്പോള് രക്തക്കുഴലുകള് പൊട്ടി രക്തസ്രാവം ഉണ്ടാകും. ഇത് ത്വക്കില്ക്കൂടി രക്തം വരാനും, ചര്മ്മത്തില് ചുവന്നപാടുകള് ഉണ്ടാകാനും കാരണമാകും.
6. രാത്രിയില് വിയര്ക്കുക..
നല്ല തണുത്ത കാലാവസ്ഥയിലും ഉറക്കത്തില് നന്നായി വിയര്ക്കുന്നത് ലുക്കീമിയയുടെ ലക്ഷണമാകാം. എന്തുകൊണ്ടാണ് ഇങ്ങനെ സംഭവിക്കുന്നതെന്ന് ഇതുവരെ വിശദീകരിക്കാന് ഡോക്ടര്മാര്ക്ക് സാധിച്ചിട്ടില്ല.
7. ഇടയ്ക്കിടെ ഉണ്ടാകുന്ന അണുബാധകള്..
ശരീരത്തില് ഇടയ്ക്കിടെ അണുബാധ ഉണ്ടാകുന്നുണ്ടെങ്കില് ശ്രദ്ധിക്കണം. അത് ചിലപ്പോള് രക്താര്ബുദത്തിന്റെ ലക്ഷണമാകാം. രക്തത്തിലെ വെളുത്തരക്താണുക്കളുടെ അളവ് കുറയുന്നതുകൊണ്ടാണ് ഇങ്ങനെ അടിക്കടി അണുബാധ ഉണ്ടാകുന്നത്.
8. ശരീര ഭാരം കുറയുക..
പെട്ടെന്ന് ശരീരഭാരം അമിതമായി കുറയുന്നതും രക്താര്ബുദത്തിന്റെ ലക്ഷണമാകാം.
മേല്പ്പറഞ്ഞ എട്ട് ലക്ഷണങ്ങളും ഉള്ളവര് രക്താര്ബുദം പിടിപെട്ടതായി കണക്കാക്കേണ്ടതില്ല. എന്നാല് ഈ ലക്ഷണങ്ങളുള്ളവര് വൈദ്യസഹായം തേടുകയും ആവശ്യമായ രക്തപരിശോധനകള് നടത്താനും തയ്യാറാകണം. തുടക്കത്തിലേ കണ്ടെത്തിയാല് രക്താര്ബുദം പൂര്ണമായും ചികില്സിച്ച് ഭേദമാക്കാം.
ഏറ്റവും പുതിയ തെരഞ്ഞെടുപ്പ് വാര്ത്തകള്, തല്സമയ വിവരങ്ങള് എല്ലാം അറിയാന് ക്ലിക്ക് ചെയ്യുക . കൂടുതല് തെരഞ്ഞെടുപ്പ് അപ്ഡേഷനുകൾക്കായി ഏഷ്യാനെറ്റ് ന്യൂസ് ഫേസ്ബുക്ക് , ട്വിറ്റര് , ഇന്സ്റ്റഗ്രാം , യൂട്യൂബ് |